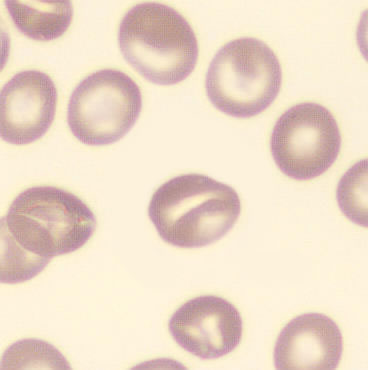

Aberrations
This section shows possible variations and deviations from "normal" for all cell lines. The clinical relevance is highly dependent on the context, degree and frequency with which the identified abnormality occurs.
Where possible, general, relevant background information is shown. It is important to check your own institute's guidelines on how to deal with a particular abnormality.
Where possible, general, relevant background information is shown. It is important to check your own institute's guidelines on how to deal with a particular abnormality.
Missing variations
Do you have images of an anomaly that are not already on this site? If so, please get in touch.